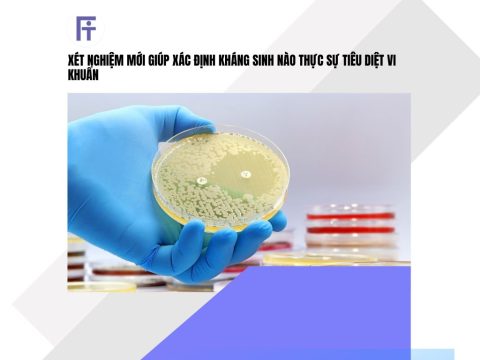

Lão hóa não bắt đầu từ đâu? Vai trò của tế bào glial và viêm
15/04/2026Bảng tóm tắt nghiên cứu về lão hóa não
| Hạng mục | Nội dung chính |
| Câu hỏi nghiên cứu | Lão hóa não do neuron hay do yếu tố khác? |
| Phạm vi phân tích | Biểu hiện gene ở nhiều loại tế bào não |
| Nhóm tế bào chính | Neuron và tế bào glial (microglia, oligodendrocytes,…) |
| Phát hiện quan trọng | Tế bào glial thay đổi mạnh hơn neuron theo tuổi |
| Cơ chế chính | Tăng viêm (inflammation) + giảm chức năng neuron |
| Mất cân bằng cốt lõi | Viêm ↑ – chức năng neuron ↓ |
| Hotspot lão hóa | Vùng hypothalamus gần não thất thứ 3 |
| Liên kết sinh học | Hypothalamus điều khiển chuyển hóa và năng lượng |
| Insight lớn | Lão hóa não = vấn đề của môi trường tế bào, không chỉ neuron |
| Vai trò chuyển hóa | Metabolism ảnh hưởng trực tiếp đến tốc độ lão hóa não |
| Ứng dụng điều trị | Nhắm vào tế bào glial và kiểm soát viêm |
| Ứng dụng lifestyle | Diet, fasting, calorie restriction có thể làm chậm lão hóa |
| Ý nghĩa dài hạn | Hướng mới trong phòng ngừa Alzheimer và bệnh thoái hóa |
Bối cảnh nghiên cứu
Lão hóa não thường được hiểu là sự suy giảm của neuron theo thời gian, dẫn đến mất trí nhớ và giảm chức năng nhận thức. Tuy nhiên, các nghiên cứu gần đây cho thấy quá trình này phức tạp hơn nhiều, không chỉ liên quan đến neuron mà còn liên quan đến các tế bào hỗ trợ và môi trường vi mô trong não. Điều này đặt ra câu hỏi liệu nguyên nhân gốc rễ của lão hóa não có nằm ở những thành phần khác ngoài neuron hay không, đặc biệt trong bối cảnh các bệnh thoái hóa thần kinh như Alzheimer ngày càng gia tăng.
Quá trình nghiên cứu
Các nhà khoa học đã phân tích sự thay đổi biểu hiện gene trong nhiều loại tế bào khác nhau của não khi lão hóa, bao gồm cả neuron và các tế bào glial như microglia, macrophages, oligodendrocytes, tanycytes và ependymal cells. Nghiên cứu tập trung vào việc xác định những khu vực và loại tế bào chịu ảnh hưởng mạnh nhất theo thời gian, đồng thời đánh giá mối liên hệ giữa các thay đổi này với viêm và chuyển hóa.
Kết quả nghiên cứu
Kết quả cho thấy các tế bào glial là nhóm chịu ảnh hưởng rõ rệt nhất trong quá trình lão hóa. Những tế bào này vốn đóng vai trò hỗ trợ neuron, duy trì môi trường ổn định và tham gia vào hệ miễn dịch của não. Khi tuổi tăng lên, biểu hiện gene liên quan đến viêm trong các tế bào này tăng mạnh, trong khi các gene liên quan đến chức năng và cấu trúc của neuron lại bị suy giảm.
Sự mất cân bằng giữa viêm và chức năng neuron được xem là yếu tố quan trọng thúc đẩy lão hóa não. Viêm mạn tính không chỉ làm tổn thương tế bào thần kinh mà còn làm gián đoạn khả năng tái tạo và kết nối của neuron.
Đáng chú ý, những thay đổi mạnh nhất được ghi nhận ở khu vực gần não thất thứ ba thuộc vùng hypothalamus, một trung tâm quan trọng điều hòa ăn uống, năng lượng và chuyển hóa. Điều này cho thấy mối liên hệ chặt chẽ giữa chuyển hóa và lão hóa não, khi các rối loạn chuyển hóa có thể trực tiếp thúc đẩy quá trình suy giảm chức năng não bộ.
Bảng: Các yếu tố chính trong lão hóa não bộ
| Yếu tố | Nội dung | Insight |
| Tế bào nhạy cảm | Các tế bào glial như microglia, macrophages, oligodendrocytes, tanycytes, ependymal thay đổi mạnh theo tuổi | Lão hóa không chỉ ở neuron |
| Vai trò tế bào glial | Hỗ trợ neuron, duy trì môi trường não | “Hệ support” quyết định sức khỏe não |
| Viêm tăng lên | Gene liên quan viêm hoạt động mạnh hơn | Inflammation = driver chính của lão hóa |
| Neuron suy giảm | Gene liên quan chức năng neuron bị ức chế | Mất cân bằng viêm – chức năng |
| Hot spot lão hóa | Vùng gần não thất 3 (hypothalamus) thay đổi mạnh nhất | Trung tâm điều khiển metabolism |
| Liên kết chuyển hóa | Hypothalamus liên quan ăn uống, năng lượng | Metabolism ảnh hưởng trực tiếp não |
| Vai trò chế độ ăn | Ăn uống có thể tác động đến tốc độ lão hóa não | Diet = công cụ can thiệp |
| Ứng dụng điều trị | Nhắm vào tế bào glial để làm chậm lão hóa | Target mới cho therapy |
| Liên hệ thực tế | Intermittent fasting, calorie restriction có tiềm năng bảo vệ não | Lifestyle có thể can thiệp sớm |
Ý nghĩa và ứng dụng
Phát hiện này mở ra một góc nhìn mới về lão hóa não, khi trọng tâm không còn chỉ là neuron mà chuyển sang các tế bào glial và trạng thái viêm. Điều này đồng nghĩa với việc các chiến lược can thiệp trong tương lai có thể tập trung vào việc kiểm soát viêm và cải thiện chức năng của các tế bào hỗ trợ này.
Ngoài ra, do hypothalamus đóng vai trò trung tâm trong chuyển hóa, các yếu tố như chế độ ăn và lối sống có thể ảnh hưởng trực tiếp đến tốc độ lão hóa não. Những phương pháp như hạn chế calo hoặc nhịn ăn gián đoạn được cho là có tiềm năng cải thiện sức khỏe não bộ thông qua việc điều chỉnh chuyển hóa và giảm viêm.
Kết luận
Lão hóa não không chỉ là sự suy giảm của neuron mà là kết quả của sự tương tác phức tạp giữa viêm, chuyển hóa và chức năng của các tế bào glial. Việc hiểu rõ những cơ chế này không chỉ giúp giải thích quá trình lão hóa mà còn mở ra cơ hội phát triển các phương pháp can thiệp mới nhằm duy trì sức khỏe não bộ và phòng ngừa các bệnh thoái hóa thần kinh trong tương lai.
Nguồn
DOI: 10.1038/s41586-024-08350-8